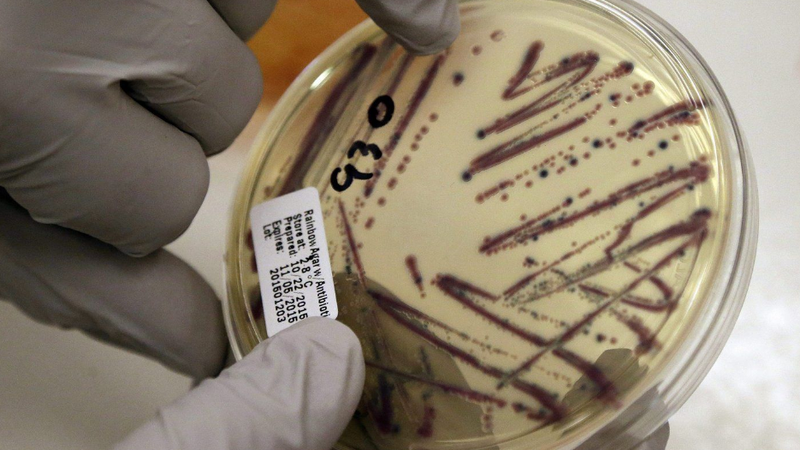

Author Archives:

Liberal MPs meet to prep for fall sitting, as Trudeau stares down slumping polls
LONDON, Ont. - Liberal MPs are gathering in London, Ont., to plan their strategy as the party grapples with rising discontentment toward Prime Minister Justin Trudeau. Polls show the Liberals have sun...
Sep 12, 2023

Jake Marshall and Nikki Stahl named Kodiaks' athletes of the week
LETHBRIDGE, AB - Last weekend was the first of the season for men's and women's soccer in the Athletic Colleges Athletic Conference (ACAC).The Kodiaks kicked it off with two home matches, and came out...
Sep 12, 2023

Province announces $5 million to support students with disabilities
LETHBRIDGE, AB - The Government of Alberta said it will support students with low incidence disabilities through new funding.It has announced $5 million for the 2023-24 school year to allow school aut...
Sep 12, 2023

One evacuation imposed, another dropped, as B.C. wildfires burn through September
VANCOUVER - The latest evacuation order issued due to a wildfire in British Columbia covers a rural area north of Prince George in a region straddling the boundaries of two regional governments. The r...
Sep 12, 2023
Critical health violations found in kitchen used by Calgary daycares after E. coli outbreak
CALGARY, AB - Alberta's chief medical officer of health says there three critical violations were found at a central kitchen serving Calgary daycares affected by an E. coli outbreak.More than 200 peop...
Sep 12, 2023

Critical health violations found in kitchen used by daycares after E. coli outbreak
CALGARY - Alberta's chief medical officer of health says there three critical violations were found at a central kitchen serving Calgary daycares affected by an E. coli outbreak. More than 200 people ...
Sep 12, 2023

McCarthy directs House panel to open Biden impeachment inquiry
WASHINGTON (AP) - Speaker Kevin McCarthy said Tuesday he is directing a House committee to open a formal impeachment inquiry into President Joe Biden over his family's business dealings, launching his...
Sep 12, 2023

Defenseman Torey Krug injured his right foot while training for the coming season, Blues say
ST. LOUIS (AP) - St. Louis Blues defenseman Torey Krug injured his right foot while training for the coming NHL season, general manager Doug Armstrong announced Tuesday. The Blues did not reveal how l...
Sep 12, 2023

It will take 20 years for feds to break even with Volkswagen, Stellantis deals: PBO
OTTAWA - The parliamentary budget officer says it will take the federal government until 2043 to break even on its EV battery deals with two automotive giants. The government announced subsidies for V...
Sep 12, 2023

Jets make centre Adam Lowry new captain, third to wear 'C' in Winnipeg history
WINNIPEG - The Winnipeg Jets have named centre Adam Lowry new team captain. Lowry scored 13 times and added 23 assists for the Jets last season. He has 93 goals and 111 assists over nine NHL seasons, ...
Sep 12, 2023